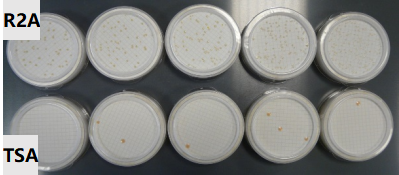
实验室纯水

实验室纯水中微生物的控制与检测
实验室纯水中微生物的控制与检测
水作为实验室不可或缺的核心“试剂”,其水质直接决定实验数据的可靠性。除了电阻率、总有机碳等常见指标,微生物含量更是影响实验结果的关键因素,尤其在高精密分析、制药、临床检测等领域,微生物污染可能引发一系列连锁问题。
一、认识纯水中的“隐形入侵者”:微生物是什么?
微生物是一类个体微小、结构简单的生物群体,涵盖真菌、细菌、病毒、小型原生生物等,它们普遍存在于自然环境中,也可能通过各种途径进入实验室纯水中。不同类型微生物的尺寸差异显著,这也为其检测和过滤控制提供了参考依据:
|
微生物类型 |
直径范围 |
|
酵母 |
4μm-50μm |
|
细菌 |
0.3μm-5μm |
|
病毒 |
0.01μm-0.3μm |
这些微小的“入侵者”肉眼不可见,却能在适宜条件下快速繁殖,成为影响实验和仪器的潜在隐患。
二、微生物污染的危害:不可忽视的实验“绊脚石”
纯水中的微生物及其代谢产物,会给实验室工作带来多方面负面影响,严重时可能导致实验失败或仪器损坏:
- 污染仪器部件:微生物会附着在分析仪器的管路、色谱柱、反应池等关键部位,形成顽固的生物膜,不仅影响仪器的正常运行,还会导致检测信号漂移、使用寿命缩短;
- 干扰实验结果:微生物代谢过程中会产生各类离子、酶、有机物等,这些物质会对有机分析、无机检测、微生物培养等实验造成干扰,引发数据偏差或假阳性结果;
- 繁殖难以控制:实验室的温度、湿度环境通常适宜微生物生长,一旦纯水系统中出现微生物,短时间内就可能大量繁殖,且形成的生物膜难以彻底清除,持续污染水质。
三、微生物控制的标准要求:不同领域有哪些规范?
为保障实验质量和产品安全,不同行业和领域对纯水中的微生物含量制定了明确标准,以下是常见的规范要求:
(一)分析实验类标准
|
标准编号 |
微生物指标 |
内毒素/热源指标 |
|
GB/T 6682-2008 |
无明确要求(NA) |
无明确要求(NA) |
|
GB/T 33087-2016 |
<10cfu/L |
无明确要求(NA) |
|
ASTMD 1193-06 |
无明确要求(NA) |
<0.25EU/ml |
(二)制药类纯化水标准
|
标准类型 |
微生物指标 |
内毒素/热源指标 |
|
中国药典 |
≤100cfu/mL |
≤0.25EU/ml |
|
EP(欧洲药典) |
≤100cfu/mL |
≤0.25EU/ml |
|
USP(美国药典) |
≤100cfu/mL |
无明确要求(NA) |
(三)临床类纯化水标准
|
标准编号 |
适用场景 |
细菌指标 |
|
CLSI(CLRW) |
临床实验用水 |
≤10cfu/mL |
|
CLSI(SRW) |
特殊实验用水 |
≤10cfu/mL |
|
CLSI(IFW) |
仪器冲洗用水 |
≤10cfu/mL |
|
WS/T574-2018 |
试剂用纯化水 |
≤10cfu/mL |
|
WS/T574-2018 |
特殊试剂用纯化水 |
≤10cfu/mL |
四、微生物的检测方法:如何精准捕捉“隐形污染”?
实验室常用膜过滤法检测纯水中的微生物,该方法操作简便、结果准确,具体步骤如下:
- 准备带滤膜(孔径通常为0.2μm)的真空过滤装置,确保装置无菌;
- 取一定体积的纯水样品,通过真空过滤使水样流经滤膜,微生物会被截留在滤膜表面;
- 用无菌镊子小心取出滤膜;
- 将其平铺在专用培养基上;
- 放入恒温培养箱中,在适宜温度(通常为28-30℃)下培养一定时间(一般为48-72小时);
- 培养结束后,对培养基上的菌落进行计数,换算出每毫升或每升纯水中的微生物含量(cfu/mL或cfu/L)。
关键实验结论:
- 培养基选择:对比R2A和TSA两种常见培养基后发现,R2A培养基更适合纯水中细菌的培养,能更准确地反映微生物污染水平;
- 系统影响:实验表明,带有紫外(UV)照射功能的纯水系统,微生物去除效果显著优于无UV系统,搭配ASM水箱使用时,可将微生物含量控制在≤1cfu/mL,而无UV和ASM的系统,微生物含量可能高达数百甚至数千cfu/mL。
五、微生物的控制技术:渗源纯水如何守护纯水洁净?
要从根源上控制纯水中的微生物,需借助科学的纯化技术。渗源纯水系统整合了两种核心纯化手段,构建全方位的微生物防护体系:
- 膜过滤技术:采用0.2μm筛网过滤器和超滤膜,利用物理拦截原理,高效截留水中的细菌、酵母等微生物,阻止其进入后续纯水系统;
- 紫外照射技术:创新采用265nm无汞紫外灯,相较于传统254nm紫外灯,杀菌效率大幅提升,能有效破坏微生物的DNA结构,抑制其繁殖。
通过膜过滤与紫外照射技术的协同作用,渗源纯水系统可全面控制纯水中的微生物生长,为实验室提供符合各行业标准的高纯度水,助力实验结果精准可靠。
想要了解更多纯水纯化技术、仪器维护技巧?欢迎关注渗源纯水官方平台,解锁全套纯水知识!若有技术疑问,可随时拨打咨询热线:400-8732-808。
同类文章排行
- 实验室超纯水机ro和up分别
- 超纯水中有多少溶解氧?
- 实验室超纯水机出水有气
- 实验室用水问题解答
- 水处理系统中的SDI是什么
- 实验室纯水机产出RO水呈酸
- 余氯含量对超纯水机耗材
- 超纯水机水质达到18.2ΩM
- 工业纯水机产水PH值偏酸性
- 什么是工业纯水?

